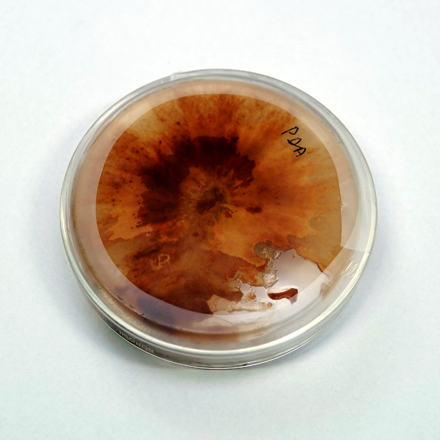

Welcome to Devleela group
Devleela Group, based at Raipur, the capital of Chhattisgarh state India. The group has emerged and spread its wings in the niche sector of microbial biotechnology. It has forayed into major key areas viz. Commercial Tissue Culture, Research and Development, Cold Storages and Food Processing. The group also has lateral interest in Real Estates.
The Group is headed by Mr. Rajendra Surana, a venerable entrepreneur connected
with various social and charitable organisations of the state and beyond.
He is ably assisted by two directors Piyush and Rajdev, who are looking after the
functioning and organisational management.


Mr. Rajendra Surana
Group Chairman
After experiencing in various business sector, Mr. Rajendra Surana founded Devleela Group in 2006. His vision for the group is the key to success of Devleela Biotechs, Devleela Lifesciences & Shree Devleela Cold & Foods. He is the National Secretary of Shri Akhil Bharatiya Sadhumargi Jain Sangh (2017-19). He started Devleela Lifecare, which promotes the donation of Stem cell. As a part of Social networking, he is the Assistant Governor of Rotary Dist. 3261 (2018-19). He is the past President of Raipur Iron & Steel Trade Association and Rotary Club of Raipur Grater.

 Buy Banana plants
Buy Bamboo plants
Buy Banana plants
Buy Bamboo plants